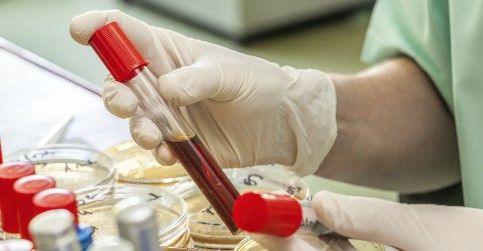
آزمایش آبله مرغان

آزمایش ویروس VZV به منظور تشخیص عفونت زونا (Varicella-Zoster Virus) استفاده میشود. این ویروس عامل بیماری زونا (چیکانپوک) است که منجر به عفونت هرپس زوستر میشود.
تبخال تناسلی و ویروس هرپس چیست؟
دو نوع آزمایش معمولاً برای تشخیص عفونت ویروس VZV انجام میشود:
1. آزمایش خون برای تشخیص آنتی بادیهای موجود: این آزمایش به منظور تشخیص آنتی بادیهای IgM و IgG موجود در خون انجام میشود. آنتی بادیهای IgM معمولاً نشان دهنده عفونت تازه است و آنتی بادیهای IgG نشان دهنده عفونت قبلی یا واکسیناسیون است. با مقایسه نتایج آزمایش با نرمافزاری که برای تفسیر آنتی بادیها استفاده میشود، میتوان عفونت جدید یا گذشته را تشخیص داد.
2. آزمایش PCR برای تشخیص حمله ویروسی: این آزمایش برای تشخیص مستقیم ویروس VZV در نمونههای مانند آبزیان، مایع منوژنیتال، ترشحات پوستی و غیره استفاده میشود. PCR (Polymerase Chain Reaction) یک روش آزمایشی است که با استفاده از تکثیر ژنتیکی میتواند حضور ویروس را تشخیص دهد.
آزمایش VZV برای تشخیص عفونت زونا در همه افراد
آزمایش VZV معمولاً برای تشخیص عفونت زونا (Varicella-Zoster Virus) استفاده میشود، اما ممکن است در برخی از موارد این آزمایش نتایج دقیق و قطعی را ارائه ندهد. در زیر به چند حالت مختلف که ممکن است باعث عدم موثری آزمایش VZV در تشخیص عفونت زونا شود، اشاره خواهم کرد:
1. واکسیناسیون قبلی: در صورتی که فرد قبلاً واکسینه شده باشد، آزمایش VZV ممکن است نتایجی نشان دهد که نشان میدهد فرد در گذشته واکسینه شده است ولی نمیتواند بگوید آیا فرد در حال حاضر عفونت دارد یا خیر.
2. عفونت قبلی: اگر فرد در گذشته با ویروس VZV عفونت داشته باشد، آزمایش ممکن است نشان دهد که فرد در گذشته عفونت داشته است، اما نمیتواند تشخیص دهد عفونت جدید وجود دارد یا خیر.
3. زمان انجام آزمایش: زمان مناسب برای انجام آزمایش VZV ممکن است نقشی در دقت و موثریت آن داشته باشد. در صورتی که آزمایش در مرحله اولیه عفونت (زونا) انجام شود، ممکن است آنتی بادیها هنوز به اندازه کافی تولید نشده باشند تا توسط آزمایش تشخیص داده شوند.
4. خلل در آزمایش: همانند هر آزمایش دیگری، ممکن است خطاهای فنی در انجام آزمایش VZV رخ دهد که به نتایج نادرست منجر شود.
بنابراین، برای دریافت تشخیص دقیق و قطعی در مورد عفونت زونا و هر نوع آزمایش تشخیصی دیگری، منابع دیگری مانند تاریخچه بیماری، علائم بالینی، و مشاوره پزشکی به همراه آزمایشهای تکمیلی ممکن است مورد نیاز باشند.

آزمایش VZV برای تشخیص عفونت در دوران بارداری
آزمایش VZV در دوران بارداری معمولاً برای تشخیص عفونت زونا (Varicella-Zoster Virus) انجام نمیشود. اگر زن باردار با عفونت زونا مواجه شود، ممکن است برای ارزیابی و مدیریت مناسب، آزمایشهای دیگری انجام شود.
در صورتی که زن باردار به تماس با فردی که عفونت زونا دارد یا با خود علائم عفونت زونا را تجربه کرده باشد، باید فوراً با پزشک خود تماس بگیرد. در این موارد، پزشک میتواند تشخیص دقیقتری بر اساس علائم بالینی و سابقه بیماری بررسی کند و در صورت لزوم تصمیمگیری در مورد آزمایش VZV یا سایر آزمایشها را انجام دهد.
اگر زن باردار علائم عفونت زونا را تجربه کند و برای تشخیص دقیقتر و مدیریت مناسب نیاز به آزمایش داشته باشد، پزشک ممکن است آزمایشهای دیگری مانند آزمایشهای خون برای تشخیص آنتی بادیها یا آزمایش PCR برای تشخیص مستقیم ویروس VZV را در نظر بگیرد. هدف از این آزمایشها، تشخیص و مدیریت صحیح عفونت در دوران بارداری است.
بنابراین، تصمیم نهایی در مورد انجام آزمایش VZV در دوران بارداری باید توسط پزشک مربوطه گرفته شود، بر اساس سابقه بیماری، علائم بالینی و نیازهای خاص هر فرد.
بیماری وبا چیست؟راه های پیشگیری از وبا را در این مقاله بخوانید.
علایم عفونت زونا
عفونت زونا (Varicella-Zoster Virus) عموماً با علائم آشنا به نام سوختگی (Chickenpox) در کودکان و بزرگسالان ظاهر میشود. اما در برخی موارد، ویروس میتواند به شکل عفونت عروقی (Shingles) در افرادی که در گذشته با عفونت زونا مواجه شدهاند، بازگردد. در ادامه علائم عفونت زونا را برای هر دو وضعیت بررسی میکنیم:
علائم عفونت زونا (سوختگی):
1. طاسیهای قرمز روی پوست که به طور تدریجی به ذرات آبی پر میشوند.
2. خارش شدید در ناحیه پوستی که طاسیها در آن شکل میگیرند.
3. تب مختصر و ملایم.
4. خستگی و ضعف عمومی.
5. درد عضلانی و مشکلات خفیف در دست و پاها.
علائم عفونت زونا (عفونت عروقی):
1. درد شدید و سوزش در ناحیه مشخصی از بدن که طیف عصبی زونا نامیده میشود. این ناحیه معمولاً در یک یا دو طرف بدن و در امتداد یک عصب خاص قرار دارد.
2. طاسیهای قرمز و دردناک که به طور تدریجی تبدیل به حوزههای پر آب، پوستی و سپس به پوستی خشک میشوند.
3. خارش، سوزش و درد در ناحیه مبتلا.
4. احساس حساسیت یا درد در مناطق نزدیک به ناحیه آسیب دیده.
5. ممکن است علائم عمومی مانند تب، خستگی و سردرد نیز وجود داشته باشد.
در صورتی که شما یا کسی که نگرانی دارید، علائمی از عفونت زونا را تجربه کردهید، بهتر است به پزشک مراجعه کنید. پزشک میتواند بر اساس علائم بالینی و سابقه بیماری شما، تشخیص دقیقی را قرار دهد و در صورت لزوم درمان مناسب را تجویز کند.
آزمایش آنتي بادي IgM آبله مرغان و زونا
آزمایش آنتی بادی IgM برای تشخیص عفونت آبله مرغان (Varicella) و زونا (Varicella-Zoster Virus) مورد استفاده قرار میگیرد. این آزمایش بررسی میکند که آیا بدن شما در معرض این ویروسها بوده و آیا سیستم ایمنی شما به آنها پاسخ داده یا خیر.
آزمایش آنتی بادی IgM، آنتی بادیهایی را که در طی عفونت توسط سیستم ایمنی بدن تولید میشوند، شناسایی میکند. این آنتی بادیها به عنوان نشانگری برای تشخیص عفونت تازه استفاده میشوند، زیرا آنتی بادیهای IgM معمولاً در مراحل اولیه عفونت تولید میشوند و به مرور زمان کاهش مییابند.
در صورتی که آزمایش آنتی بادی IgM برای آبله مرغان انجام شود و نتیجه مثبت باشد، این نشان میدهد که شما تازهً به آبله مرغان مبتلا شدهاید یا در معرض آن بودهاید.
همچنین، اگر آزمایش آنتی بادی IgM برای زونا انجام شود و نتیجه مثبت باشد، این نشان میدهد که شما در حال حاضر در معرض عفونت زونا هستید و بدن شما در حال ساختن آنتی بادیهای IgM مرتبط با این ویروس است.
مهم است بدانید که نتایج آزمایش آنتی بادی IgM باید توسط پزشک تشریح شود. پزشک شما میتواند بر اساس نتایج آزمایش، علائم بالینی و سابقه بیماری شما تشخیص دقیقتری را قرار دهد و در صورت لزوم درمان مناسب را تجویز کند.
مقادیرطبیعی:
Negetive : <9.0
Grey zone : 9.0-11.0
Positive : >11.0
روشهای درمانی برای زونا و آبله مرغان
البته لازم به ذکر است که درمان عفونت زونا و آبله مرغان ممکن است بسته به شدت عفونت و وضعیت بیمار متفاوت باشد. در ادامه، روشهای درمانی معمول برای هر دو عفونت را توضیح میدهم:
1. درمان آبله مرغان:
– بیماران با آبله مرغان معمولاً نیازی به درمان ویژه ندارند، مگر اینکه شرایط خاصی مانند سیستم ایمنی ضعیف داشته باشند.
– در صورت بروز خارش شدید، میتوان از محافظتکنندههای پوستی مانند کرمها و لوسیونهای ضدخارش استفاده کرد.
– استفاده از ضدتبهکاران مانند استامینوفن (پاراستامول) میتواند به کاهش تب و درد عضلانی کمک کند.
– در موارد خاص و شدیدتر، پزشک ممکن است داروهای ضدویروسی مانند آسیکلوویر یا والاسیکلوویر را تجویز کند تا مدت زمان عفونت را کوتاهتر کند و علائم را کاهش دهد.
2. درمان زونا:
– در بسیاری از موارد، زونا به طور خودبخود بهبود مییابد. با این حال، در صورتی که علائم شدید یا طولانیمدت باشند، درمان درمانی لازم است.
– داروهای ضدویروسی مانند آسیکلوویر، فامسیکلوویر و والاسیکلوویر معمولاً برای کاهش شدت علائم و مدت زمان بیماری تجویز میشوند. این داروها باید در مدت زمان مشخص و به دستور پزشک مصرف شوند.
– در صورت درد شدید، میتوان از ضد دردها مانند استامینوفن یا آبتامینوفن استفاده کرد.
– برخی داروهای دیگر مانند آنتیاستروئیدها و آنتیهیستامینها نیز میتوانند در برخی موارد خاص تجویز شوند.
– در صورت بروز عفونت ثانویه، ممکن است پزشک داروهای ضدباکتری مانند آنتیبیوتیکها را تجویز کند.
مهم است که درمان عفونت زونا و آبله مرغان توسط یک پزشک تجویز و نظارت شود. بهتر است با پزشک خود در مورد روش درمانی مناسب برای شما صحبت کنید درمان عفونت زونا و آبله مرغان ممکن است بسته به شدت عفونت و وضعیت بیمار متفاوت باشد.
روشهای درمانی معمول برای هر دو عفونت آبله مرغان و زونا
1. درمان آبله مرغان:
– بیماران با آبله مرغان معمولاً نیازی به درمان ویژه ندارند، مگر اینکه شرایط خاصی مانند سیستم ایمنی ضعیف داشته باشند.
– در صورت بروز خارش شدید، میتوان از محافظتکنندههای پوستی مانند کرمها و لوسیونهای ضدخارش استفاده کرد.
– استفاده از ضدتبهکاران مانند استامینوفن (پاراستامول) میتواند به کاهش تب و درد عضلانی کمک کند.
– در موارد خاص و شدیدتر، پزشک ممکن است داروهای ضدویروسی مانند آسیکلوویر یا والاسیکلوویر را تجویز کند تا مدت زمان عفونت را کوتاهتر کند و علائم را کاهش دهد.
2. درمان زونا:
– در بسیاری از موارد، زونا به طور خودبخود بهبود مییابد. با این حال، در صورتی که علائم شدید یا طولانیمدت باشند، درمان درمانی لازم است.
– داروهای ضدویروسی مانند آسیکلوویر، فامسیکلوویر و والاسیکلوویر معمولاً برای کاهش شدت علائم و مدت زمان بیماری تجویز میشوند. این داروها باید در مدت زمان مشخص و به دستور پزشک مصرف شوند.
– در صورت درد شدید، میتوان از ضد دردها مانند استامینوفن یا آبتامینوفن استفاده کرد.
– برخی داروهای دیگر مانند آنتیاستروئیدها و آنتیهیستامینها نیز میتوانند در برخی موارد خاص تجویز شوند.
– در صورت بروز عفونت ثانویه، ممکن است پزشک داروهای ضدباکتری مانند آنتیبیوتیکها را تجویز کند.
مهم است که درمان عفونت زونا و آبله مرغان توسط یک پزشک تجویز و نظارت شود.
آیا واکسنی برای جلوگیری از زونا و آبله مرغان وجود دارد؟
بله، واکسنهایی برای جلوگیری از زونا و آبله مرغان وجود دارد. در ادامه به توضیحات کوتاهی درباره واکسنهای هر یک از این عفونتها میپردازم:
1. واکسن آبله مرغان:
واکسن آبله مرغان برای جلوگیری از ابتلا به آبله مرغان استفاده میشود. این واکسن معمولاً در کودکان به صورت تزریقی تجویز میشود. در بسیاری از کشورها، جمعیت در دوران کودکی با واکسن آبله مرغان پوشانده میشود تا از بروز آبله مرغان جلوگیری شود. این واکسن باعث تقویت سیستم ایمنی بدن در برابر ویروس آبله مرغان میشود و احتمال ابتلا و شدت عفونت را کاهش میدهد.
2. واکسن زونا:
واکسن زونا (نام تجاری: زوستاواکس) برای جلوگیری از عفونت زونا استفاده میشود. این واکسن بر اساس ویروس واکسن آبله مرغان تضعیف شده تولید میشود. با تزریق واکسن زونا، سیستم ایمنی بدن به ویروس زونا عادی واکسن شده و در صورت برخورد با ویروس واقعی زونا، به طور معمول قادر به مقابله با آن است. واکسن زونا به عنوان یک محافظت برای افراد بالای 50 سال و یا افرادی که قبلاً عفونت زونا داشتهاند توصیه میشود.
چه گروههای سنی دیگری باید از واکسن زونا استفاده کنند؟
در حال حاضر، در بسیاری از کشورها، واکسن زونا (نام تجاری: زوستاواکس) به عنوان یک محافظت برای افراد بالای 50 سال در نظر گرفته میشود. اما در برخی موارد خاص، افرادی که در 50 سالگی یا جوانتر هستند نیز ممکن است به واکسن زونا نیاز داشته باشند. این شامل افرادی است که:
1. سابقه عفونت زونا را داشتهاند: اگر شما قبلاً عفونت زونا داشتهاید، در آینده ممکن است عفونت دوباره به شما برسد. در این صورت، واکسن زونا میتواند به شما کمک کند تا سطح محافظت خود را بالا ببرید.
2. سابقه آبله مرغان را داشتهاند: افرادی که قبلاً آبله مرغان داشتهاند، ممکن است در معرض خطر بیشتری قرار بگیرند که عفونت زونا را تجربه کنند. در این موارد، واکسن زونا میتواند به شما کمک کند تا از عوارض عفونت زونا پیشگیری کنید.
اگر شما یا عزیزانتان در این دسته از افراد قرار دارید، بهتر است با پزشک خود یا مراجعه به مراکز بهداشت محلی درباره نیاز واکسیناسیون با واکسن زونا مشورت کنید. آنها میتوانند براساس وضعیت شما و سابقه پزشکی شما توصیههای مناسب را به شما ارائه دهند.
آیا واکسن زونا عوارض جانبی خاصی دارد؟
بله، همانند هر واکسن دیگری، واکسن زونا هم ممکن است عوارض جانبی داشته باشد. اکثر عوارض جانبی واکسن زونا نسبتاً کوتاهمدت و خفیف هستند و اغلب خودبهخود برطرف میشوند. برخی از عوارض جانبی معمول واکسن زونا شامل موارد زیر میشوند:
1. تورم، درد و قرمزی در محل تزریق: این عوارض معمولاً در محل تزریق واکسن ظاهر میشوند و در عرض چند روز بهبود مییابند.
2. خستگی و ضعف: بعضی از افراد پس از تزریق واکسن زونا خستگی و ضعف موقتی احساس میکنند که به طور معمول در عرض چند روز بهبود مییابد.
3. سردرد: سردرد ممکن است یکی از عوارض جانبی کوتاهمدت واکسن زونا باشد، اما به طور کلی بسیار شایع نیست و به تدریج بهبود مییابد.
4. درد عضلانی و مفصلی: برخی افراد ممکن است درد و آزار عضلات و مفاصل را به عنوان عارضه جانبی احساس کنند. این عارضه معمولاً در عرض چند روز بهبود مییابد.
5. افزایش دمای بدن: در برخی از موارد، واکسن زونا ممکن است باعث افزایش دمای بدن شود. این عارضه معمولاً طی چند روز بهبود مییابد و ممکن است با استفاده از داروهای ضدتبعیض مانند استامینوفن کنترل شود.
مهم است بدانید که عوارض جانبی برای هر فرد ممکن است متفاوت باشد و نه همه افراد با آنها مواجه میشوند. در صورت تجربه هرگونه عارضه ناخواسته یا نگرانی، بهتر است با پزشک خود یا مراجعه به مراکز بهداشت محلی تماس بگیرید.انجام آزمایش در آزمایشگاه تشخص طبی استاندارد و مجهز در شناسایی موارد ذکر شده بسیار مفید خواهد بود.



بدون دیدگاه